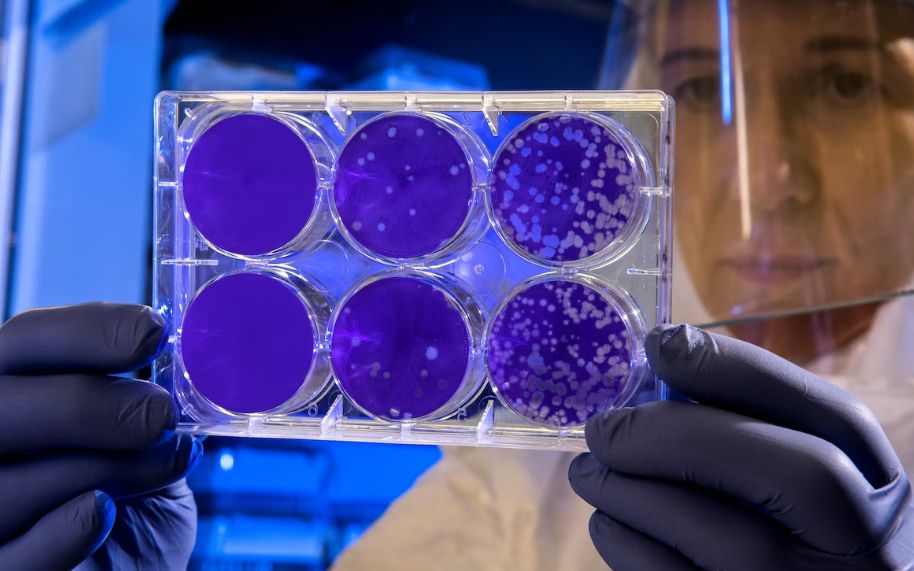
Oamenii De Stiinta Au Modificat Celulele Umane Pentru A Produce Insulina Si Au Reusit Sa Vindece Diabetul

Oamenii de știință au modificat celulele umane pentru a produce insulină și au reușit să vindece diabetul în testele preliminare
Oamenii de știință au transformat celulele stomacale umane în țesuturi care eliberează insulină ca răspuns la creșterea nivelului de zahăr din sânge, într-o descoperire care promite o modalitate eficientă de a gestiona afecțiuni precum diabetul de tip 1.
Experimentul, condus de cercetătorii de la Weill Cornell Medicine din SUA, a arătat că transplanturile de celule gastrice secretoare de insulină au inversat evoluția diabetul la șoareci.
În mod normal, celulele beta pancreatice au rolul de a elibera hormonul insulină ca răspuns la nivelurile ridicate de zahăr din sânge. La persoanele cu diabet, aceste țesuturi sunt deteriorate sau mor, compromițând capacitatea lor de a muta glucoza în celule pentru a le servi drept combustibil.
Deși celulele gastrice secretoare de insulină nu sunt celule beta, ele pot imita funcția acestora. Astfel, speranța este aceea că cei care suferă de diabet ar putea avea propriile celule stem intestinale transformate în acest tip de celule gastrice, limitând astfel riscul de respingere.
„Stomacul își produce propriile celule secretoare de hormoni, iar celulele gastrice și pancreatice sunt adiacente în stadiul embrionar de dezvoltare, astfel încât, în acest sens, nu este complet surprinzător faptul că celulele stem gastrice pot fi transformate atât de ușor în celule secretoare de insulină de tip beta", spune Joe Zhou, profesor asociat de medicină regenerativă la Weill Cornell Medicine din New York.
Oamenii de știință au încercat să facă să funcționeze așa ceva de mulți ani, însă fără un succes real. În cadrul acestei investigații, echipa a activat trei proteine specifice din celule care controlează manifestarea genelor, într-o anumită ordine, pentru a declanșa o transformare în celule secretoare de insulină.
Procesul de reprogramare este foarte eficient, iar atunci când celulele au fost cultivate în grupuri mici acestea au arătat sensibilitate la glucoză. Ulterior, au fost apoi capabile să arate efecte de lungă durată asupra influențării evoluției diabetului la șoareci.
Producerea de celule secretoare de insulină din celule stomacale nu este un proces deosebit de complicat, spun cercetătorii. Este nevoie doar de câteva zile pentru a se întâmpla, iar aceste noi celule pot rezista timp de mai multe luni după ce au fost transplantate, pe baza testelor lor.
Această abordare este încă la început, dar ar permite organismului să gestioneze din nou nivelurile de insulină în mod apropiat de cel natural.
___________________________________________________________________________________________________
Urmăriți emisiunile preferate pe protvplus.ro: